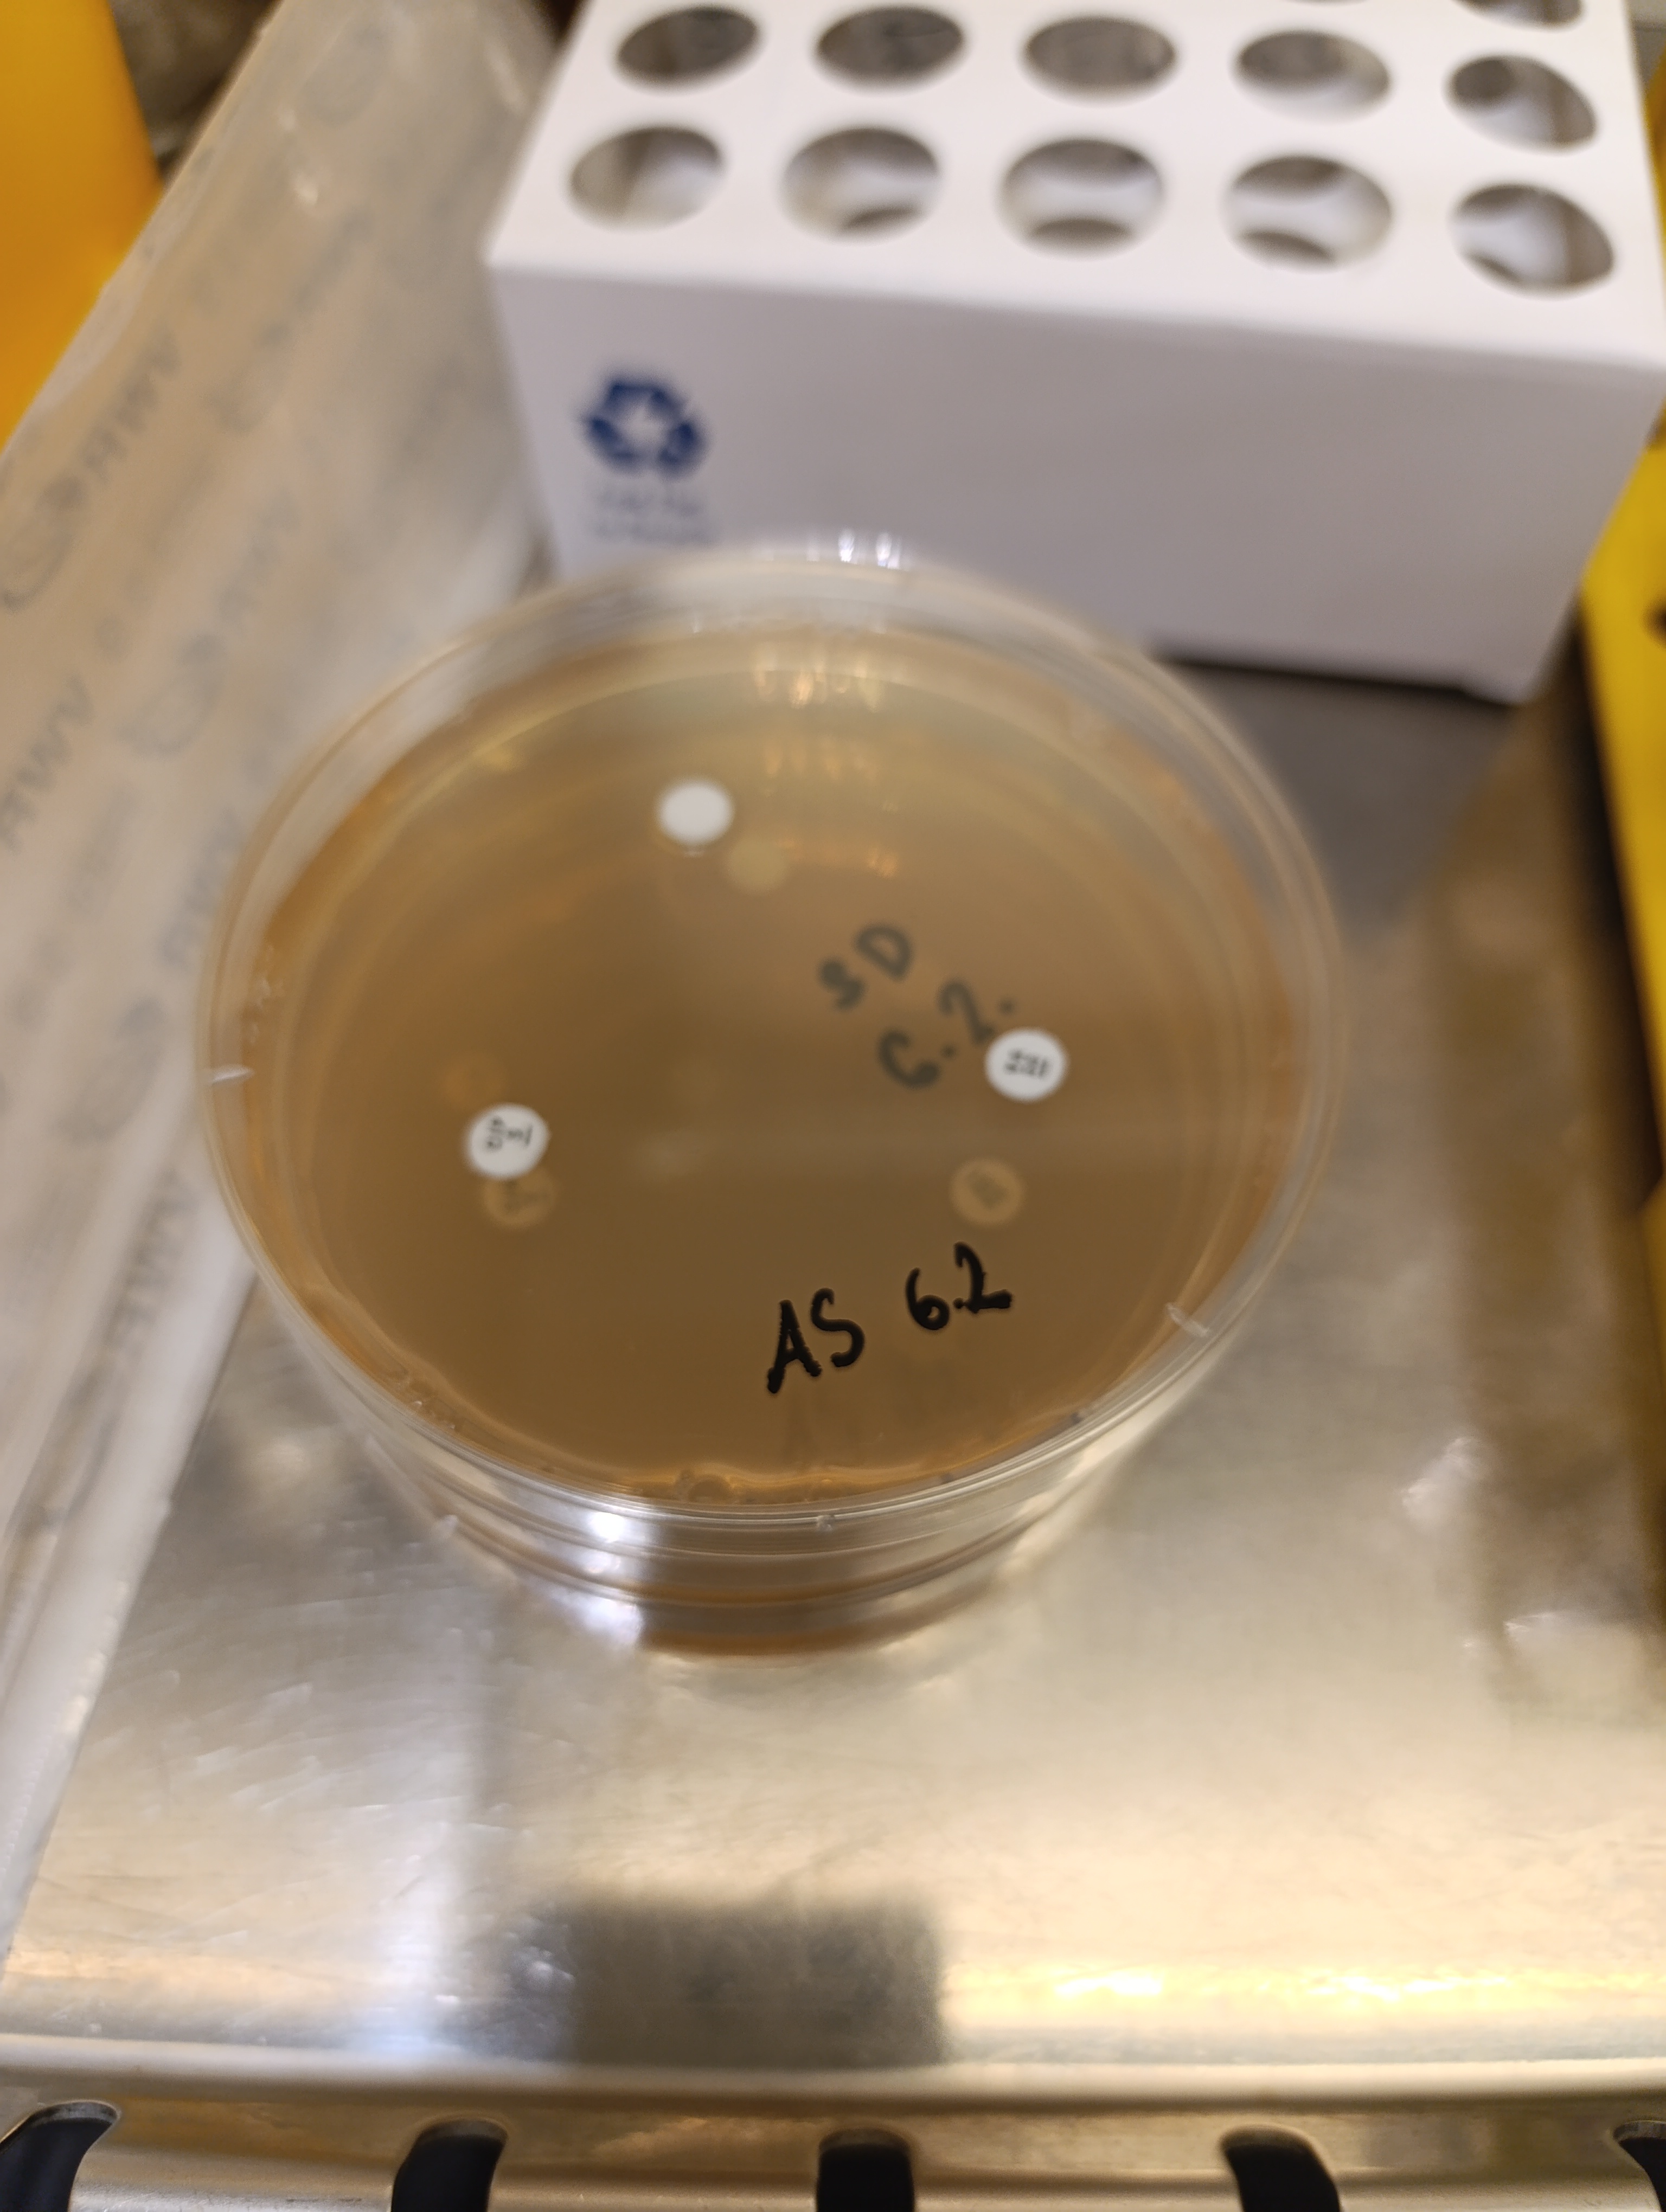

Přijď si s námi užít prezentaci našeho výzkumu na STEAM Slam 2026!
„Děkuji za to, že jsme mohli každé setkání pracovat přímo v laboratoři, bez velkých teorií."
Co se dělo na setkáních:
27. 2. 2026 Týmová práce na projektu: návrh řešení konkrétního ekologického problému pomocí mikroorganismů

6. a 13. 2. 2026 Neviditelný nepřítel: testujeme antibiotickou rezistenci a minimální inhibiční koncentraci antibakterální látky na bakterie
Princip testování: Kirby-Bauerova metoda - diskový difuzní test. Naučili jsme se, že šířka zóny bez bakterií kolem antibiotického disku rozhoduje o úspěchu léčby.
Precizní laboratoř: připravili jsme standardizovanou suspenzi, rovnoměrně naočkovali Mueller-Hintonův agar a rozmístili disky s antibiotiky.
Interpretace výsledků: Po inkubaci jsme měřili průměry inhibičních zón a pomocí mezinárodních tabulek EUCAST určovali, zda je bakterie citlivá (S), intermediární (I), nebo rezistentní (R).
Hlubší souvislosti: Diskuse se stočila k mechanismům účinku antibiotik (např. jak ničí buněčnou stěnu bakterií) a k varovnému šíření rezistence v populaci. Zajímaly nás i technické detaily, jako je vliv tloušťky agaru nebo koncentrace vzorku na přesnost výsledku.

23. 1. 2026 Očkování bakterií na Petriho misku, křížový roztěr a měření optické denzity bakterií
Analýza metodou MALDI-TOF: seznámili jsme se s principy moderní techniky a sledovali praktickou ukázku měření i interpretace proteinového spektra bakterií.
Měření enzymatické aktivity: Pomocí spektrofotometru jsme sledovali odbarvování modrého barviva dřevokaznou houbou a výsledky porovnávali s kontrolním vzorkem (blankem).
Mikrobiologické techniky: vyzkoušeli jsme si očkování bakterií technikou křížového roztěru a rovnoměrné roztírání probiotických kultur (Lactobacillus a Bifidobacterium) pomocí sterilní hokejky.
Práce se suspenzemi: Součástí úkolů byla příprava ředicí řady bakterií a následné měření jejich optické denzity na fotometru.
„ Baví mě praktická část, zejména křížový roztěr a práce se sterilní hokejkou.“


16. 1. 2026 Biotechnologie a čištění vod
Věnujeme se enkapsulaci mycelií dřevokazných hub (outkovka pestrá – Trametes versicolor) a testování jejich schopnosti rozkládat farmaceutické polutanty (modelové léčivo Coldrex).
Biotechnologické postupy: Příprava alginátové směsi a tvorba stabilních gelových kapsul.
Práce s laboratorní technikou: Obsluha analytických vah, magnetických míchaček a sonikace v ultrazvukové lázni.
Metodika výzkumu: Příprava experimentu pro dlouhodobé sledování biodegradace léčiv pomocí enzymů hub.
Odborný přehled: Pochopení role mikroorganismů a řas při ekologickém čištění odpadních vod.
Každodenní realita vědecké práce, financování grantů a využití AI ve výzkumu.
Kariérní možnosti v biotechnologiích, environmentální chemii a analytických laboratořích.
Význam interdisciplinarity (propojení biologie, chemie a datové analýzy).
„ Oceňuji možnost pracovat s reálným biologickým materiálem a vidět přímou aplikaci laboratorních technik při řešení globálních environmentálních problémů.“


9. 1. 2026 Stanovení bílkovin a antioxidační aktivity u dřevokazných hub
Laboratorní analýza: zkoumali jsme bílkoviny a antioxidanty v dřevokazných houbách. K měření jsme využili dvě klíčové metody (Bradfordové a Biuretovou) a pro srovnání analyzovali i běžné mléko.
Práce s technologiemi: Hlavním nástrojem byl spektrofotometr. Vytvářeli jsme kalibrační křivky, vyhodnocovali naměřená data a interpretovali výsledky.
Teorie v praxi: Diskutovali jsme o tom, jak houby bojují s oxidačním stresem a jak se jejich antioxidanty využívají ve farmacii, potravinářství nebo biotechnologiích.
Kariérní rozhled: Velká část setkání patřila diskuzi o budoucnosti. Kde studovat biologii a chemii v ČR? Jaké jsou možnosti stáží a uplatnění v komerční sféře (výzkum, vývoj, laboratoře)?


19.12.2025 Aktivity enzymů z dřevokazných hub
Stanovujeme aktivitu enzymů lakázy a lignin peroxidázy pomocí UV-VIS spektrofotometru a sledujeme změny absorbance.
Porovnáváme čisté kultury hub s miskami kontaminovanými kvasinkami.
Učíme se významu sterilní práce v laboratoři.
Diskutujeme využití lipáz, například v lapačích tuků v domácnostech.


28. 11. 2025 Mikrobiální hrdinové!
Diskutujeme roli hub, bakterií a kvasinek v rozkladu znečišťujících látek a v udržitelném nakládání s odpady. Co je enzym? Co je pufr? Co je transferáza? Co je troudnatec?
Jak tyto organismy využít v praxi, například při čištění vody nebo půdy? Zjistili také, že kvalita vody může být překvapivá – například kohoutková voda je často kvalitnější než ta balená, která bývá zatížena nejen plastovým odpadem, ale někdy i nižší kontrolou.
A potom už jsme pipetovali a sledovali neviditelný mikrosvět... který má obrovský význam pro zdravou přírodu i náš každodenní život.

